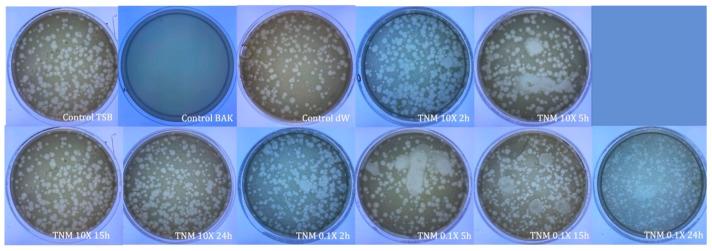
https://cdn.ncbi.nlm.nih.gov/pmc/blobs/5bd1/10419018/a735bffa49ce/ijms-24-12018-g010.jpg
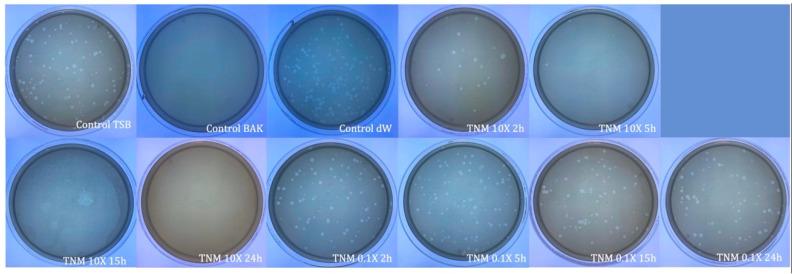
https://cdn.ncbi.nlm.nih.gov/pmc/blobs/5bd1/10419018/d9b80c639cd9/ijms-24-12018-g004.jpg

虎坚果奶对有包膜和无包膜病毒的抗病毒特性:浓度和加糖的影响。
Tiger Nut Milk's Antiviral Properties against Enveloped and Non-Enveloped Viruses: Effect of Concentration and Adding Sugar.
机构信息
Biomaterials and Bioengineering Lab, Centro de Investigación Traslacional San Alberto Magno, Universidad Católica de Valencia San Vicente Mártir, 46001 Valencia, Spain.
出版信息
Int J Mol Sci. 2023 Jul 27;24(15):12018. doi: 10.3390/ijms241512018.
The global COVID-19 pandemic has warned scientists of the requirement to look for new antimicrobial compounds to prevent infection by this type of viral pathogen. Natural compounds are becoming a promising avenue of research thanks to their renewable, biodegradable, and non-toxic properties. In this work, tiger nut milk's (TNM) antiviral properties, with and without sugar, were studied against enveloped and non-enveloped viruses. The antiviral properties of TNM were evaluated at different concentrations. The antiviral tests showed that TNM is antiviral against the enveloped bacteriophage phi 6, which is commonly used as a surrogate for severe acute respiratory syndrome coronavirus 2 (SARS-CoV-2), although it did not have any antiviral effect against the non-enveloped bacteriophage MS2. We also found that adding sugar to this natural drink can improve its antiviral properties against enveloped viruses and render it antiviral against non-enveloped viruses like bacteriophage MS2. The antiviral activity of TNM depends on the TNM concentration. TNM is a natural bioproduct that could help to fight against viral infections and protect against a wide range of viral illnesses. These results confirm that the typical sweetened drink made from tiger nut extract and sugar (known as horchata in Spain) possesses broad-spectrum antiviral properties.
全球 COVID-19 大流行警示科学家,需要寻找新的抗菌化合物来预防此类病毒病原体的感染。由于天然化合物具有可再生、可生物降解和无毒的特性,因此成为了极具前景的研究方向。在这项工作中,研究了带糖和不带糖的虎坚果奶(TNM)对包膜和非包膜病毒的抗病毒特性。评估了 TNM 在不同浓度下的抗病毒特性。抗病毒测试表明,TNM 具有抗包膜噬菌体 phi 6 的作用,phi 6 通常被用作严重急性呼吸综合征冠状病毒 2(SARS-CoV-2)的替代物,尽管它对非包膜噬菌体 MS2 没有任何抗病毒作用。我们还发现,向这种天然饮料中添加糖可以提高其对包膜病毒的抗病毒特性,并使其对非包膜病毒(如噬菌体 MS2)具有抗病毒作用。TNM 的抗病毒活性取决于 TNM 的浓度。TNM 是一种天然的生物制品,可以帮助对抗病毒感染,并预防多种病毒性疾病。这些结果证实,由虎坚果提取物和糖制成的典型加糖饮料(在西班牙称为 horchata)具有广谱抗病毒特性。